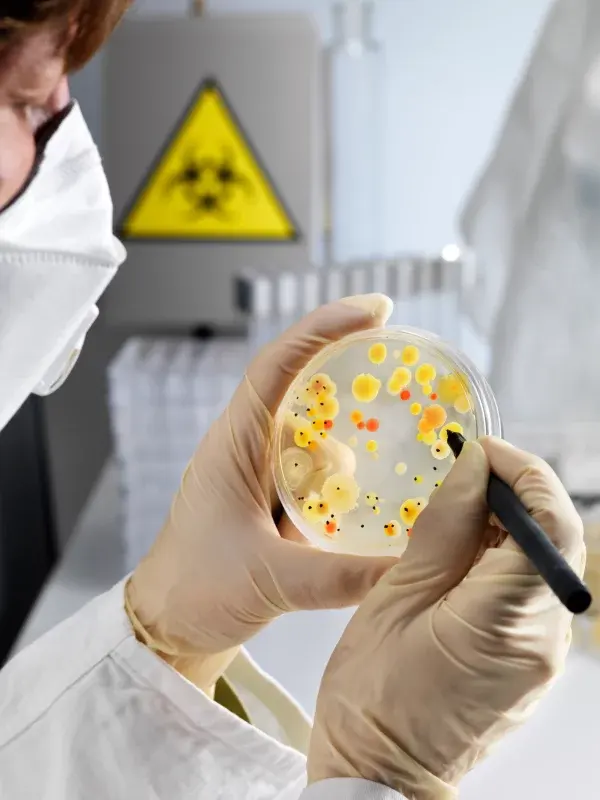
Laborantin mit Mund-Nasen-Schutz und Handschuhen hält Petrischale mit gelben und roten Bakterienkolonien und markiert sie mit Stift.

Biosicherheits-Räume (Aerosol)
Automatisierte 3D-Raumdesinfektion in Biosicherheitsräumen
Medizinbereich (Aerosol)
Automatisierte 3D-Raumdesinfektion in Medizin & Pflege
Raumhygiene (Aerosol)
Lückenlose 3D-Raumdesinfektion in der Raumpflege
Biosicherheits-Räume (Aerosol)
Automatisierte 3D-Raumdesinfektion in Biosicherheitsräumen
Verkehrsmittel (Aerosol)
Automatisierte 3D-Raumdesinfektion in Verkehrsmitteln
Automatisierte Raumdesinfektion in Labor- und GMP-Räumen
In Labors stellt die Kontamination von Proben durch luftgetragene Keime oder Kreuzkontaminationen ein häufiges Problem dar. Unter Umständen müssen ganze Versuchsreihen deshalb entsorgt und wiederholt werden. Zusätzlich besteht das Risiko, dass im Falle einer unabsichtlichen Freisetzung pathogener Keime die Gesundheit von Menschen und Umwelt gefährdet wird.
In Produktionsräumen der Pharmaindustrie besteht zudem die Gefahr, dass Produktionschargen mit Keimen verunreinigt werden.
Die Aerosoldesinfektion stellt eine effektive Ergänzung zur herkömmlichen Flächendesinfektion in der Raumhygiene dar und hilft, Hygienelücken gezielt zu schliessen. Dabei werden Desinfektionsmittel in Form feiner Partikel in die Luft versprüht, um auch schwer erreichbare Stellen wie die Raumluft und schwer zugängliche Flächen gründlich zu desinfizieren. Auf diese Weise kann eine umfassende Entkeimung von Oberflächen erfolgen, die sonst möglicherweise übersehen würden.
Sanosil Desinfektionsmittel für die Aerosol-Desinfektionsanwendung: eine gute Wahl!
Die Kombination aus speziell für diesen Zweck entwickelten Geräten (Sanosil Q-Jet Serie) und den passenden Sanosil Desinfektionsmitteln hat sich für die 3D-Ganzraumdesinfektion seit über 25 Jahren hervorragend bewährt.
- erstklassige Produkte mit geboostetem Wasserstoffperoxid
- geprüfte Wirksamkeit (Norm EN 17272 / AFNOR NFT 72-281)
- seit über 25 Jahre im Einsatz
- ISO 13485 Medical Standard gefertigte Produkte verfügbar
- Verwendbar mit den Sanosil Q-Jet Geräten oder bauähnlichen, für die automatisierte Aerosol/ Kaltnebeldesinfektion bewährte Fremdgeräten
Die Sanosil – Bestseller für die 3D-aHP Ganzraumdesinfektion
Geräte

Sanosil Q-Jet C10
Kompaktes Aerosol-Gerät für die 3D Hygiene in Räumen von 6 – 100m³
- moderne 3D – Ganzraumdesinfektion durch automatisiertes, luftgetragenes System (Aerosoldesinfektion)
- handlich, einfach zu Transportieren & Betreiben
- Kompressortechnologie: leise und zuverlässig
- ideal für Zimmer / kleinere Räume bis 100m3

Sanosil Q-Jet CT20
Gebrauchsfertiges Desinfektionsmittel für Oberflächen - mit sehr rascher Wirkung
- moderne 3D – Ganzraumdesinfektion durch automatisiertes, luftgetragenes System (Aerosoldesinfektion)
- mit Kompressor und zuschaltbarer Turbine für kleine bis grosse Räume
- Dosierungsmöglichkeit auch über die Sättigungsgrenze der Raumluft hinaus dank automatische zuschaltbarer Stepfunktion
- für anspruchsvolle Aufgaben wie Desinfektionen unter EN 17272 Bedingungen
Aerosol- Desinfektionsmittel

Sanosil S015
Desinfektionsmittel für anspruchsvolle Aerosolanwendungen mit AFNOR NFT 72-281 Prüfung
- Wirksamkeit gegen Bakterien, Viren, Hefen, Pilze und Sporen
- automatische Raumdesinfektio-Anwendung mit den Sanosil Q-Jet Geräten oder baugleich / funktionsähnlich
- mit katalytisch verstärktem Wasserstoffperoxid (zerfällt zu Wasser und Sauerstoff)
- Alternative zu VPHP (verdampfes Wasserstoffperoxid) – ohne ADR-Beschränkungen

Sanosil QDis8
Desinfektionsmittel (silberfrei) für anspruchsvolle Aerosolanwendungen mit EN - 17272 Prüfung
- Wirksamkeit getestet Norm EN 17272 gegen Bakterien, Viren, Hefen und Pilze
- automatische Raumdesinfektio-Anwendung mit den Sanosil Q-Jet Geräten oder baugleich / funktionsähnlich
- mit synergistisch verstärktem Wasserstoffperoxid (zerfällt zu Wasser und Sauerstoff), silberfrei
- Alternative zu VPHP (verdampfes Wasserstoffperoxid) – ohne ADR-Beschränkungen
Häufig gestellte Fragen(FAQ)
Eignet sich die automatisierte, luftgetragene Raumdesinfektion (AADS) auch für Reinräume?
Ja, EU GMP Annex 1 von 2022 empfiehlt diese explizit.

Was ist der Unterschied zwischen Wasserstoffperoxid – Aerosolsystemen (aHP) und Systemen mit verdampftem H2O2 (VpHP)?
- VpHP – Verdampftes H2O2 (Dampfphasen-Wasserstoffperoxid). Verdampft eine 30–35 %ige wässrige Wasserstoffperoxid-Lösung, um ein Gemisch aus Heissluft und Wasserstoffperoxid-Dampf zu erzeugen.
- aHP – Aerosol (aerosolisiertes Wasserstoffperoxid)
Erzeugt einen Nebel durch Aerosolisierung einer Lösung, die eine geringere Konzentration an Wasserstoffperoxid (weniger als 8 %) sowie verstärkende chemische Zusätze (z. B. katalytisch wirkende Silberionen, Stabilisatoren) enthält.

Was sind die Vorteile der Sanosil Aerosol-Desinfektion (aHP) gegenüber verdampftem Wasserstoffperoxid (VpHP)?
- Generatoren sind deutlich günstiger
- weniger empfindlich gegenüber kleinen Spuren von Schmutz, Staub oder Biofilmen
- benutzerfreundliche Bedienung und Handhabung
- konzipiert, um auch von nicht fachkundigem Personal bedient zu werden
- weniger empfindlich gegenüber klimatischen Bedingungen
- einfache Handhabung auch in nicht gasdicht verschlossenen Räumen
- Betrieb mit tiefer konzentrierten H2O2-Produkten (7,5 – 8%) möglich – Kein Gefahrgut, keine ADR Transport- und Lagervorschriften

Werden elektronische Geräte durch eine Aerosoldesinfektion mit geboostetem Wasserstoffperoxid geschädigt?
Verschiedene unabhängige Studien sowie unsere eigenen Erfahrungen zeigen, dass elektronische Geräte wie PCs, Tablets, Flachbildschirme, Mobiltelefone und ähnliche Geräte durch eine Aerosoldesinfektion mit Wasserstoffperoxid nicht beeinträchtigt werden. Im Gegensatz dazu können Chlordioxid- oder Peressigsäure-Lösungen die Funktion und Integrität elektronischer Geräte negativ beeinflussen.

Ist eine sporozide Log 5-6 Reduktion mit dem Q-Jet CT-20 und Sanosil S015 möglich?
Ja, mit entsprechender Dosierung und Programmierung ist dieses Ziel erreichbar.

Wie lange dauerte eine Aerosoldesinfektion mit den Q-Jet Geräten?
Die benötigte Zeit setzt sich aus zwei Komponenten zusammen: A) der Sprühzeit – also der Zeit, die benötigt wird, um eine bestimmte Menge Desinfektionsmittel in einem Raum zu vernebeln, und B) der notwendigen Einwirk- und Zerfallszeit. Während der Einwirkzeit werden die Keime aktiv reduziert. Gleichzeitig baut sich das Wasserstoffperoxid ab und zerfällt in Wasser und Sauerstoff. Dieser Prozess dauert mindestens 120 Minuten.

Kann eine Aerosoldesinfektion die klassische Reinigung oder manuelle Sprüh-Wischdesinfektion ersetzen?
Nein, das ist nicht möglich. Die Aerosoldesinfektion bietet im Vergleich zur Wischdesinfektion zwar eine lückenlose und damit bessere Abdeckung aller Oberflächen, verfügt jedoch über eine begrenzte Eindringtiefe. Schon kleinste Schmutzrückstände können die Wirksamkeit einer aHP-Desinfektion deutlich reduzieren, weshalb eine gründliche Vorreinigung unerlässlich ist.
Die Aerosoltechnologie stellt eine zusätzliche Sicherheitsstufe beziehungsweise Massnahme zur Eindämmung mikrobiologischer Risiken dar.

Kann eine Aerosoldesinfektion in Anwesenheit von Menschen (oder Tieren) durchgeführt werden?
Nein das ist nicht möglich. (Ausser sie sind durch eine ABEK-P3 Vollschutzmaske geschützt.)

Was sind die Vorteile der Sanosil Desinfektionsmittel mit geboostetem Wasserstoffperoxid gegenüber anderen für diesen Zweck genutzten Produkten?
Sanosil Q-Dis (und S015) eignen sich hervorragend für die Ganzraumdesinfektion. Sie…
- verursachen weniger Gesundheitsrisiken und Probleme als verdampftes Formaldehyd
- automatische Raumdesinfektio-Anwendung mit den Sanosil Q-Jet Geräten oder baugleich / funktionsähnlich
- sind einfacher in der Zyklusetablierung und sicherer im Umgang als H2O2 – Dampfsysteme (VpHP)
- begünstigen keine Keimresistenzen wie QAV – Produkte
- verfügen über umfassende geprüfte Wirksamkeit (Norm EN 17272 / AFNOR NFT72-281) – Dies im Gegensatz zu den meisten Systemen mit Anolyt, Aktivchlor oder hypochloriger Säure





